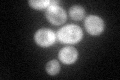
YKR071C
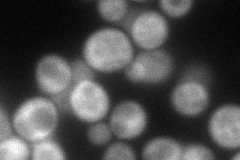
YKR071C
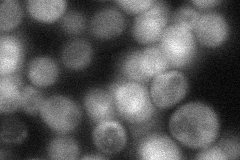
YKR071C
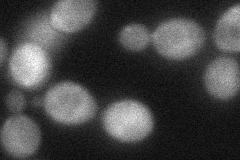
YKR071C
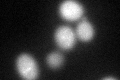
YKR071C
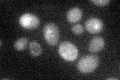
YKR071C

View description
Protein that may prevent apoptosis by forming a complex with Tah18p in the absence of stress; required for iron-sulfur cluster assembly and sister chromatid cohesion; homolog of human anti-apoptotic protein Ciapin1
Localization:
Intensity:
Fold change:
Significance:
-
C’ GFP library in SD
cytosol46.89 -
N' NOP1pr-GFP in SD

cytosol77.6609 -
N' TEF2pr-mCherry in SD
cytosol77.4397 -
N' NATIVEpr-GFP in SD
cytosol45.161 -
N' TEF2pr-VC and Cyto-VN in SD
cytosol46.3866 -
C’ GFP library in SD+DTT
cytosol44.590.95No -
C’ GFP library in SD+H2O2

cytosol72.281.54Yes -
C’ GFP library in Starvation Media
cytosol41.290.88No -
C’ GFP library on the background of Pup2-DaMP

cytosol -
C’ GFP library on the background of CCT mutant

cytosol46.89861No
